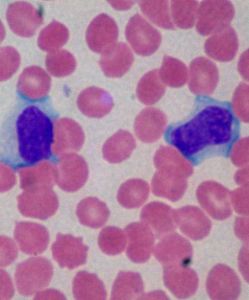
傳染性黃疸 傳染性黃疸

流行病學
病變細胞症狀和體徵
潛伏期2~20日(通常7~13日),本病的特徵為兩階段性.第一階段為敗血症期,起病突然,有頭痛,嚴重肌痛,寒戰和發熱.結膜充血是其特徵,通常在第3或第4天出現.肝腫大和脾腫大不常見.本階段可持續4~9日,可有反覆的寒戰和發熱,體溫常高達>39℃.隨後退熱,在病程的第6至第12日開始第二階段,也稱免疫階段,此階段血清中出現抗體.發熱和早期的症狀又重現,並可出現腦膜炎體徵.第7天后檢查腦脊液,至少發現50%的病人有淋巴細胞增多.少數可發生虹膜睫狀體炎,視神經炎和周圍神經病.若在懷孕期獲本病,即使在恢復期,也可引起流產.
Weil綜合徵(黃疸性鉤端螺鏇體病)是一種鉤端螺鏇體病的嚴重型,表現為黃疸並通常伴有氮質血症,出血,貧血,神志不清和持續發熱.開始的症狀與非嚴重型相似,從第3至第6日出現肝細胞和腎功能障礙.腎功能異常包括蛋白尿,膿尿,血尿和氮質血症.出血症狀系由毛細血管受損所致.血小板減少也可發生.肝臟受損輕微,可以完全恢復.
任何血清型鉤端螺鏇體感染均有可能發生無菌性腦膜炎.腦脊液細胞計數為10~1000/μl(通常<500/μl),以單核細胞為主.腦脊液的葡萄糖正常,蛋白<100mg/dl.大多數無菌性腦膜炎病人無明顯的肝腎疾病表現.
卡尼可拉熱(Canicolafever)是眾多鉤端螺鏇體地理株中的一種,但在臨床上和流行病學上與其他鉤端螺鏇體無區別.
實驗室檢查
多數病例白細胞計數正常或略升高,但嚴重的黃疸病例可高達50000/μl,白細胞>15000/μl提示肝臟受累,中性白細胞>70%可鑑別鉤端螺鏇體病與病毒性疾病.黃疸病人的血管內溶血可引起明顯貧血.血清膽紅素濃度通常<342μmol/L,但嚴重感染時可達684μmol/L.這些檢查結果表明肝腎受累.
診斷和預後
發現病原體或血清學陽性可確診.應在疾病的早期採血作培養,並在疾病的急性期獲取血清標本作血清學試驗.在病程的第1階段得到的血,尿或腦脊液接種到Fletcher,EMJH或吐溫80白蛋白培養基,可分離出鉤端螺鏇體.第1周后,經培養或暗視野檢查可發現尿中的鉤端螺鏇體.僅在潛伏期後2~5日,就可用BACTEC460系統作放射測定檢測人血中的鉤端螺鏇體.在病程的第3或第4周應獲取恢復期血清作血清學試驗,包括間接螢光抗體和高度敏感特異的酶聯免疫吸附試驗(ELISA)和斑點ELISA.
鑑別診斷包括腦膜炎或腦膜腦炎,流感,肝炎,急性膽囊炎和腎功能衰竭.由腸病毒所致的無菌性腦膜炎通常無兩階段病程史,這種兩階段病程史提示系鉤端螺鏇體或巨細胞病毒感染.對任何有可能接觸鉤端螺鏇體的患者出現不明原因的發熱均應考慮是否為鉤端螺鏇體病.
預防和治療
在流行接觸期每周1次口服200mg強力黴素可預防本病.病人不必隔離,但病人的尿液必須小心妥善地處理.對急性期感染,抗生素治療有效,即使治療開始相對較晚也仍有效.重症病例可用青黴素G600萬~1200萬u/d靜脈滴注或氨苄青黴素500~1000mg每6小時靜脈注射1次.對次嚴重病例,可用強力黴素100mg每日2次,氨苄青黴素500~750mg每6小時1次或阿莫西林500mg每6小時1次口服,共5~7日.重症病人的支持療法,包括液體和電解質治療也很重要.